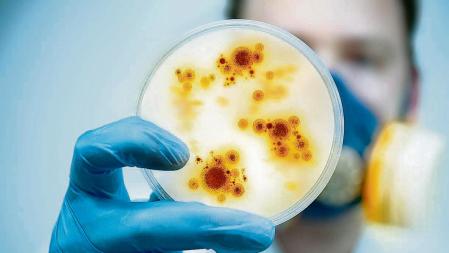
Horizontal

Microbiota hasta en la sopa. No hay que buscar muy lejos para encontrar esta palabra: no solo en alimentos funcionales de empresas lácteas o cerveceras, sino también en productos del hogar, farmacéuticos, cosméticos y hasta en champús. Incluso hay competencia por ostentar el secreto a la mejor receta sopera que reponga nuestra microbiota intestinal, esa extensa población de microorganismos donde predominan diferentes filos de bacterias, acompañados de virus, protozoos y hongos.
Y si cuidamos nuestra microbiota, uno espera que la microbiota nos cuide a nosotros también. Porque esta relación milenaria y simbiótica –kyosei, como dicen los japoneses– desempeña funciones esenciales en el control de la fisiología del huésped, es decir, en nosotros mismos. Modula no solo nuestro metabolismo y sistema inmune, sino que además puede influir nuestro estado de ánimo, nuestra forma de pensar y de actuar.
Microbiota y envejecimiento, toda una vida juntos
Ortega y Gasset lo tenía claro: “Yo soy yo y mis circunstancias”. Sin quitarle la razón, hoy me atrevería a añadir “Yo soy yo y mi microbiota”. Este binomio comienza en el día uno de nuestra existencia –cuando empezamos a ser colonizados por esa comunidad microbiana– y no deja de evolucionar con nosotros hasta el final.
La edad nos envejece a la vez a nosotros y a nuestra microbiota. Hay quien sólo analizando el estado de esta última, puede “adivinar” cómo nos está afectando el paso del tiempo. Es lo que se conoce como edad biológica, la cual puede no corresponder con la que indica el DNI.
La composición microbiana de los centenarios, individuos cuya longevidad es excepcional, parece tener rasgos diferenciales característicos
Así, la composición microbiana de los centenarios, individuos cuya longevidad es excepcional, parece tener rasgos diferenciales característicos frente al resto de la población. No solo la dieta, el ejercicio, el sueño y los medicamentos, sino también el clima, la geografía, la cultura o los contactos sociales son algunos de los múltiples factores que regulan el estado de nuestra microbiota y pueden indicar cómo la estamos cuidando.
Aunque tantas variables hacen que sea complejo definir lo que se considera un microbioma saludable, su relación con el envejecimiento es tan estrecha que, analizando el estado de la microbiota, algunos autores afirman que pueden predecir hasta el riesgo de morir.
El efecto rejuvenecedor de los trasplantes de microbiota fecal
Siguiendo estas ideas, Marcus Boehme y sus colaboradores demostraron en 2021 que el trasplante de microbiota (fecal) procedente de animales jóvenes (donantes) sobre animales de edad avanzada (receptores) revertía en estos últimos determinados síntomas asociados al envejecimiento. El trasplante de microbiota fecal fue aprobado en 2023 por la FDA (Administración de Alimentos y Medicamentos estadounidense) para tratar la infección recurrente causada por la bacteria Clostridioides difficile, ofreciendo unos resultados asombrosos frente a otros tratamientos.
En un intento por rejuvenecer con salud, los efectos del trasplante de microbiota se están caracterizando en diferentes modelos experimentales. Los investigadores han demostrado que donantes (jóvenes o saludables) transfieren mejoras metabólicas, hepáticas, del estado físico y neuroprotectoras en receptores de edad avanzada.
El cuerpo de un ser humano contiene un kilo y medio de bacterias.
La propiedad inversa también aplica aquí: cuando el donante es mayor y el receptor joven, este último padece un desequilibrio de la microbiota intestinal, un aumento de la permeabilidad de la membrana intestinal, estrés oxidativo, inflamación y alteraciones de la memoria y del aprendizaje espacial.
Un grupo de investigadores del Instituto IMDEA Alimentación en colaboración con la Universidad Complutense de Madrid hemos publicado una revisión científica para valorar el potencial de los trasplantes de microbiota fecal enfocados en la longevidad. Nuestra revisión abarca 92 ensayos clínicos controlados en población humana en los que esa técnica se utiliza para inducir mejoras en el envejecimiento y en enfermedades crónicas asociadas como sarcopenia, patologías neurodegenerativas o cáncer, entre otras.
De estos 92 ensayos, 70 de ellos (el 75 %) incluyen entre los receptores pacientes mayores de 70 años, poniendo de manifiesto la capacidad que tendría el trasplante como herramienta para transferir longevidad saludable.
Nuestra revisión abarca 92 ensayos clínicos en los que esa técnica (trasplante de microbiota fecal) se utiliza para inducir mejoras en el envejecimiento y en enfermedades crónicas asociadas
Retos pendientes
Pero tengamos sentido común. Si bien es un campo de investigación en auge e incluso resulta hipnótico, el uso clínico actual de los trasplantes de microbiota fecal todavía tiene muchas limitaciones. Uno de los principales desafíos es el panorama regulatorio: están considerados como un producto medicinal en Reino Unido y un producto biológico en América del Norte. En cuanto a Europa, es un producto de células y tejidos humanos en algunos países europeos, un medicamento en otros e incluso carece de regulación en varios Estados de la UE.
La estandarización de protocolos en el método de administración y las posibles complicaciones asociadas (como, por ejemplo, en la sedación y endoscopia o colonoscopia, enema, etc.) O los riesgos para la salud derivados de potenciales efectos a largo plazo o la transmisión de organismos patógenos son otros de los retos que requieren mejoras.
A pesar de estas limitaciones, concebir el microbioma intestinal como un actor central que influye en nuestro propio envejecimiento e imaginar que puede constituir en sí misma una herramienta para modular el proceso de envejecer es, simplemente, seductor.
Alberto Díaz-Ruiz es Jefe de Grupo, Laboratorio de Gerontología Celular y Molecular, IMDEA ALIMENTACIÓN. Marta Garrido Novelle es profesora Ayudante y doctora de la Universidad Complutense de Madrid.
Este artículo se publicó originalmente en The Conversation.
" width="100%" scrolling="no" frameBorder="0">


